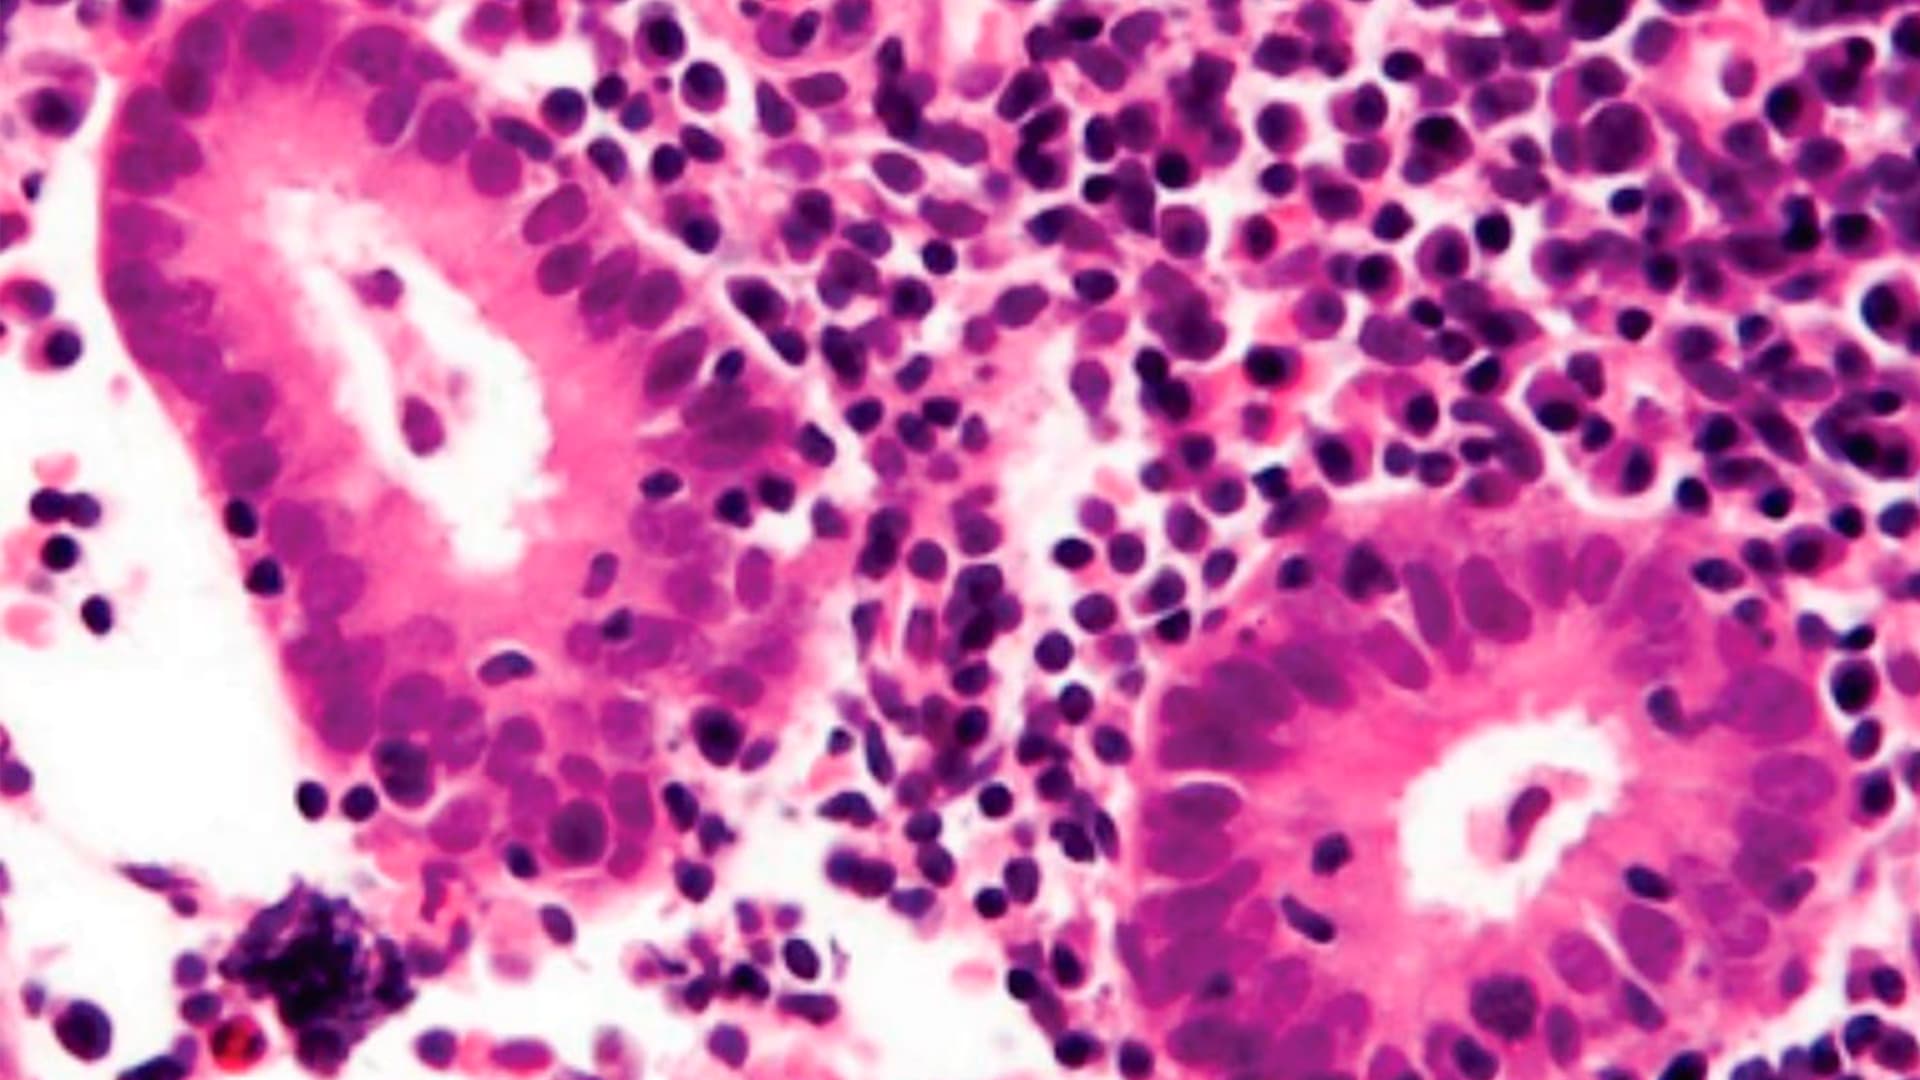
Efectos de la Endometritis Crónica en la Función Reproductiva

De GinExeltis
Efectos de la Endometritis Crónica en la Función Reproductiva
Descripción: Las pacientes con endometritis crónica a menudo están asintomáticas, o tienen síntomas inespecíficos como sangrado uterino anormal, dolor pélvico, dispareunia y leucorrea. El tratamiento oportuno de la endometritis tiene como potencial mejorar la implantación en el embarazo, aumentar las tasas de nacidos vivos y por tanto disminuir el porcentaje de abortos, en aquellas pacientes que sufren trastorno de infertilidad.
El endometrio es un órgano de tejido compuesto por 3 capas: una capa subserosa externa, una capa intermedia miometrial y la capa más interna endometrial. La capa interna está compuesta por 2 capas de membrana mucosa que contiene tanto glándulas como estroma y se compone de un estrato basal interno y un estrato funcional externo. El estrato funcional es el que responde a los cambios hormonales. Se cree que el estrato funcional además se divide en una capa inferior y una superior que está metabólicamente preparada para la posible implantación del blastocisto.
La endometritis se refiere al proceso que involucra inflamación de la capa endometrial y se clasifica de acuerdo con la histopatología, en agua o crónica. En la endometritis aguda se pueden distinguir neutrófilos y microabscesos, en contraste a la endometritis crónica en donde hay células plasmáticas en el estroma, aumento de la densidad, edema y fibroblastos.
Se estima una prevalencia de la endometritis crónica de alrededor del 11% y la mayoría de las pacientes son asintomáticas, aunque otras pueden experimentar sangrado uterino anormal, sangrado poscoital, amenorrea, dolor pélvico, dismenorrea, leucorrea, dispareunia, síntomas urinarios e infertilidad.
Alrededor del 2 al 56% de las mujeres que sufren de infertilidad, padecen endometritis crónica. El diagnóstico puede demorar ya que no siempre se decide realizar una biopsia endometrial o histeroscopia.
Aún no se conoce la causa exacta, pero se asume que es debido a microrganismos, aunque no se ha identificado uno exclusivamente. La endometritis crónica lleva a una disfunción entre el ciclo menstrual y la respuesta inmune, en específico los linfocitos CD138.
Entre los antibióticos que están indicados para el tratamiento, el mayormente aceptado es la doxiciclina 100 mg cada 12 horas por 14 días. Al dar tratamiento, podemos mejorar la implantación del embarazo y por lo tanto disminuir la posibilidad de aborto en las mujeres que sufren de infertilidad.
Fuente: Lea CG, McGovern PG. The Effect of Chronic Endometritis on Reproductive Function. Topics in Obstetrics & Gynecology. March 15. Vol 42. No. 4, 2022.
5261
